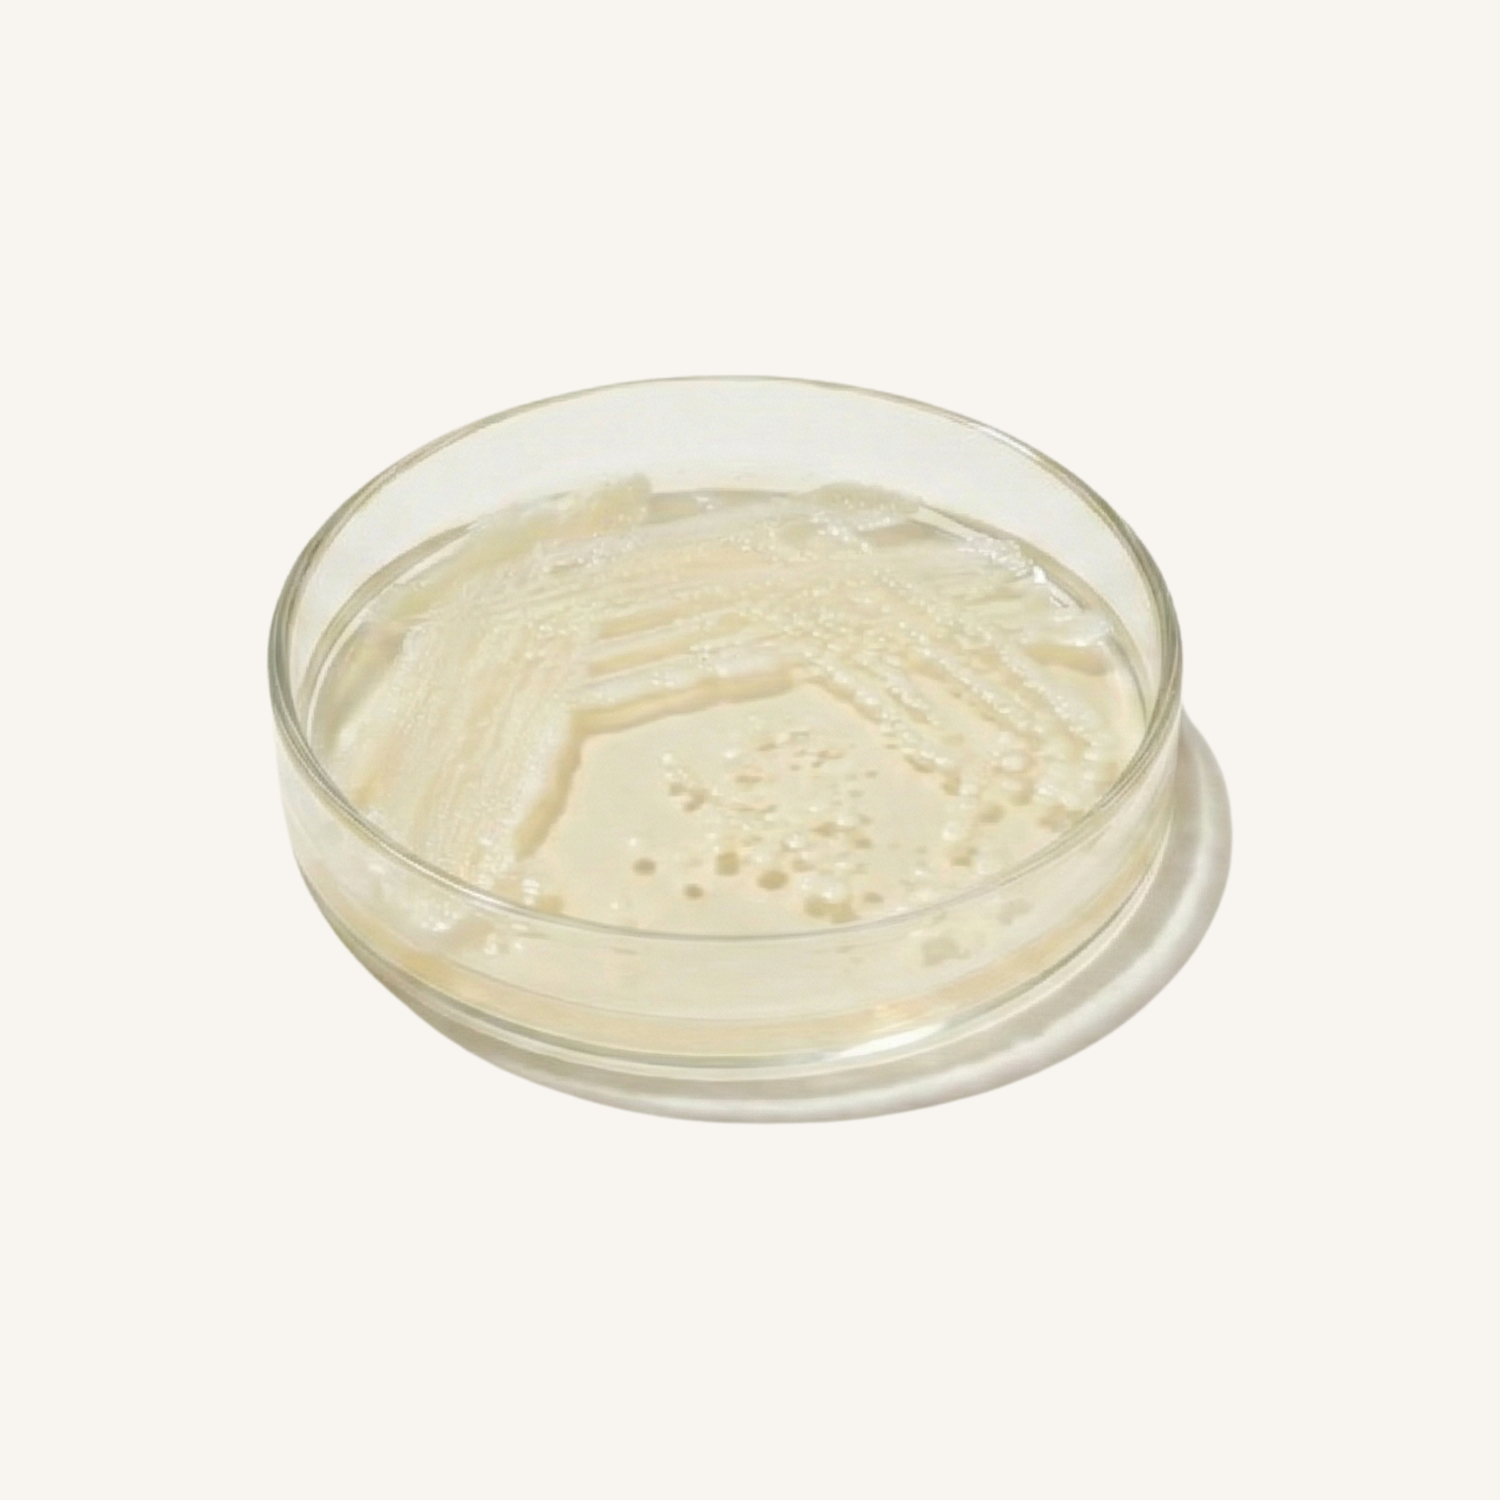

Apple Cider Vinegar Complex
gluten-free
non gmo
vegan
All the gut-balancing benefits of ACV with added probiotics and enzymes—no harsh taste, just smooth digestion.
Enjoy all the gut-balancing benefits of apple cider vinegar without the sharp taste or acidity. Each serving delivers 1,000 mg of ACV powder, combined with inulin prebiotic fiber, a Lactobacillus acidophilus probiotic (1 billion CFU), and a blend of digestive enzymes, to support digestion, gut balance, and normal metabolism. This thoughtfully crafted formula helps nourish good bacteria, support nutrient absorption, and ease occasional bloating — making digestive wellness a smooth and easy part of your daily routine.
Supplement Facts

Shipping & Returns
Orders are processed in 2–5 business days and ship from the U.S. with tracking provided. Delivery takes 1–4 business days (Standard US), 1–3 days (Express US), and 2–5 days for international orders (customs may cause delays).
If your product arrives damaged, misprinted, or defective, we’ll replace or refund it at no cost—just contact us within 30 days. Please note: returns aren’t accepted for incorrect addresses, unclaimed packages, or buyer’s remorse.





The Science Behind it
Apple cider vinegar has long been valued for its role in digestion and metabolic health. In capsule form, you get the same benefits without the harsh taste. Each serving delivers 1,000 mg of ACV powder combined with a supportive blend of prebiotics, probiotics, and digestive enzymes. The prebiotic inulin nourishes good bacteria in the gut, while Lactobacillus acidophilus helps maintain microbiome balance. Added digestive enzymes support better nutrient absorption and ease occasional bloating. Together, these ingredients create a formula that supports healthy digestion, balanced metabolism, and overall gut wellness.
Inside the Formula:
How They Work Together
Digestive Ease
1000mg of ACV powder with digestive enzymes promotes smooth digestion without the harsh vinegar taste. Enhanced with probiotics and prebiotics for comprehensive digestive support.
Cardio Support
Apple cider vinegar traditionally supports cardiovascular wellness and healthy circulation. Combined with beneficial nutrients that promote heart health and normal blood flow.
Sugar Control
ACV helps support healthy glucose metabolism and normal sugar levels. The convenient capsule form makes it easy to incorporate this traditional wellness support into your daily routine.



Got Questions?
How to Take it
Take 2 capsules daily with water, preferably before a meal. This provides 1,000 mg of apple cider vinegar plus added prebiotics, probiotics, and digestive enzymes. Consistency is key for best results.
What's Inside?
Each serving delivers:
Apple Cider Vinegar (1,000 mg) — supports digestion, metabolism, and gut balance
Inulin (prebiotic fiber) — nourishes beneficial gut bacteria
Lactobacillus acidophilus (1 billion CFU) — probiotic strain that helps maintain a balanced microbiome
Digestive Enzyme Blend — promotes nutrient absorption and eases occasional bloating
Who's it For?
This formula is designed for anyone who wants to:
Support healthy digestion and reduce occasional bloating
Maintain a balanced gut microbiome
Promote metabolic health and energy balance
Enjoy the benefits of apple cider vinegar without the taste or acidity
Safety & Quality
Manufactured in the USA, this product is made in a facility that meets rigorous standards (FDA-registered, GMP). It’s dairy-free, allergen-free, hormone-free, corn-free, and non-GMO—providing clean, trusted probiotics for daily use.
FAQ
Can I take this with other supplements?
Yes — Pure Probiotic is generally safe to take alongside other supplements. In fact, probiotics often complement multivitamins, herbal formulas, and digestive support products. If you are taking prescription medications or have specific health concerns, we recommend checking with your healthcare provider.
How soon will I notice results?
Everyone’s microbiome is unique, but many people report feeling improvements like reduced bloating or better digestion within 2–4 weeks of consistent use. For lasting benefits such as stronger immunity and balanced gut health, continued daily use is recommended.
Is this safe for long-term use?
Yes. Probiotics are safe and effective for daily, long-term use. Pure Probiotic is designed to help maintain a balanced gut microbiome as part of your ongoing wellness routine.
Become part of the Prema Family
Join the thousands finding their natural rhythm with us.




































Shop The Full Collection